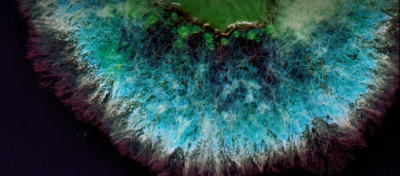

L'Oréal Groupe se asocia con Abolis y Evonik para ampliar el desarrollo de ingredientes de nuevo generación basados en biología
L'Oréal ha anunciado hoy un acuerdo tripartito con el innovador en biotecnología Abolis Biotechnologies y el fabricante global de especialidades, Evonik, para permitir el descubrimiento, desarrollo y fabricación de ingredientes innovadores y sostenibles para productos de belleza y más allá. Este acuerdo facilitará la producción de ingredientes sostenibles hechos a medida a la escala necesaria para satisfacer la demanda global de belleza responsable, acelerando los compromisos de sostenibi

